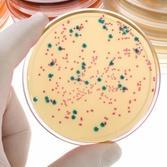
Što su aflatoksini?

20.02.2013 |
Pauza / ŽIVOT I ZDRAVLJE
Izvor: eKapija.ba
Aflatoksini su, kao što im i samo ime kaže, toksični spojevi. Nastaju kao produkt metabolizma gljivica, točnije plijesni roda Aspergillus, pa se prema tome nazivaju još i mikotoksinima (grč. mýkes - gljivica). Radi se o vjerojatno najpoznatijim i najistraženijim toksinima na svijetu.

Aflatoksini su, kao što im i samo ime kaže, toksični spojevi. Nastaju kao produkt metabolizma gljivica, točnije plijesni roda Aspergillus, pa se prema tome nazivaju još i mikotoksinima (grč. mýkes - gljivica). Radi se o vjerojatno najpoznatijim i najistraženijim toksinima na svijetu, a ljudima su zanimljivi budući da se povezuju s mnogim bolestima kod domaćih životinja i ljudi. Razlog njihove istraženosti je taj što aflatoksini pokazuju mutagena, kancerogena i teratogena svojstva. Ukoliko je organizam izložen ovim spojevima tijekom duljeg vremena, čak i u malim količinama, mogu biti opasni za ljudsko zdravlje.
Iza naziva aflatoksin krije se nekoliko spojeva slične kemijske strukture, od kojih se B1 smatra najopasnijim.
Purani su prvi stradali
Ovi spojevi su otkriveni 1960. godine kada je na engleskim farmama u samo nekoliko mjeseci uginulo više od 100 000 purana. Nova bolest nazvana je imenom Turkey X disease (hrv. X bolest purana). Međutim, nije prošlo puno vremena te se uvidjelo da bolest nije ograničena samo na purane - zahvatila je patke i fazane. Temeljita istraga bolest je povezala s hranom koju su životinje jele - brazilskim orahom (Bertholletia excelsa). Pokazalo se da orah ubija i druge životinje na isti način kao i purane. Vrlo brzo je otkriveno da se radi o gljivicama i to vrsti Aspergillus flavus. Prema njoj su aflatoksini i dobili ime - A. flavus = Afla.
Orašasti plodovi su najčešće kontaminirani
A. flavus, zajedno s još jednom vrstom istog roda, A. parasiticus, u najvećoj su mjeri odgovorne za aflatoksine. Uz povoljnu temperaturu i vlažnost zraka ove plijesni rado rastu na različitim vrstama kao što su kikiriki, suho voće, orašasti plodovi (bademi, orasi, pekan orasi, pistacija, brazilski orasi) te začini i žitarice (najčešće kukuruz). Također, ovi spojevi se mogu naći i u proizvodima životinjskog podrijetla - mlijeku i mesu. Do toga dolazi ukoliko je hrana kojom su se životinje hranile bila njima kontaminirana.
Proizvodnja aflatoksina je optimalna pri relativno višim temperaturama pa je prema tome i najveća opasnost od kontaminacije u toplim i vlažnim klimatskim područjima. Ipak, iako se tropske i suptropske regije Afrike, Azije i Južne Amerike smatraju problematičnim područjima, aflatoksini se mogu pronaći i u umjerenim područjima Sjeverne Amerike i Europe.
Posljedice za životinje i ljude
Kakve će biti posljedice kontaminacije toksinima kod životinja ovisi o mnogo faktora - vrsti životinje, dobi, spolu i prehrani. Istraživanja su pokazala da su mlađe životinje podložnije ozbiljnijim posljedicama, iako ni starije nisu imune na aflatoksine. Posljedice mogu varirati od gastrointestinalne disfunkcije i smanjene reproduktivnosti do anemije i žutice. Ipak, aflatoksini u organizmu najviše utječu na jetru.
Kod ljudi duga izloženost aflatoksinima dovodi do visokog rizika za razvitak raka jetre, ali izloženost ovim spojevima najopasnija je za djecu budući da može dovesti do zaostataka u razvoju.
Prevencija
Jedina mogućnost borbe protiv ovih opasnih spojeva jest prevencija, i to prevencija prilikom uzgoja hrane. Tijekom sakupljanja i skladištenja hrane potrebno je voditi se smjernicama uz pomoć kojih se prisutnost štetnih plijesni i aflatoksina minimalizira. Glavni faktori o kojima ovisi hoće li se plijesan razviti su temperatura i vlaga. Ukoliko se o njima vodi računa, problema ne bi trebalo biti.
Isto tako, treba spomenuti da postoje istraživanja koja su pokazala kako određene bakterije mliječne kiseline mogu ukloniti znatne količine mikotoksina iz mlijeka, što je ohrabrujući podatak.
Za kraj, obzirom na opasnosti aflatoksina, pohvalno je što su nadležna ministarstva pravovremeno reagirala.
(ordinacija.hr)
*Pri preuzimanju teksta s portala Akta.ba potrebno je navesti izvor i linkovati tekst.
Dojavi vijest na viber +387 60 331 55 03 ili na mail urednik@akta.ba.